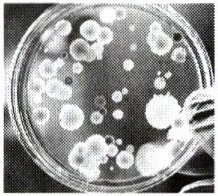

3. 如图所示,在培养细菌的过程中,小明发现培养基上出现了几种不同类型的菌落。下列选项是细菌菌落的是(
A.菌落小,表面光滑黏稠
B.菌落大,呈绒毛状
C.菌落大,呈青绿色
D.菌落大,呈絮状
A
)A.菌落小,表面光滑黏稠
B.菌落大,呈绒毛状
C.菌落大,呈青绿色
D.菌落大,呈絮状
答案:
A
4. 某海关在进口食品检疫中发现一种病原微生物,这种病原微生物为单细胞生物,具有细胞壁,细胞内没有成形的细胞核。这种生物最可能属于(
A.真菌
B.细菌
C.酵母菌
D.病毒
B
)A.真菌
B.细菌
C.酵母菌
D.病毒
答案:
B
5. 下列生物中,都属于真菌的一组是(
A.灵芝、噬菌体、马勃
B.葡萄球菌、青霉菌、酵母菌
C.平菇、毒红菇、毒蝇伞
D.曲霉菌、大肠杆菌、腺病毒
C
)A.灵芝、噬菌体、马勃
B.葡萄球菌、青霉菌、酵母菌
C.平菇、毒红菇、毒蝇伞
D.曲霉菌、大肠杆菌、腺病毒
答案:
C
6. (2024 遵义中考)夏季气温升高,食物容易腐败变质,这是由于在适宜条件下细菌、霉菌等微生物大量繁殖,其中霉菌的主要繁殖方式是(
A.分裂生殖
B.孢子生殖
C.出芽生殖
D.自我复制
B
)A.分裂生殖
B.孢子生殖
C.出芽生殖
D.自我复制
答案:
B
7. (2025 廊坊开学考试)2024 年 8 月 14 日,世界卫生组织再次宣布,猴痘疫情构成“国际关注的突发公共卫生事件”。猴痘病毒经黏膜和破损的皮肤侵入人体,能引起发热、淋巴结肿大和全身水疱脓疱,并伴有出血倾向,危害人类健康。下列有关猴痘病毒的叙述,正确的是(
A.能离开活细胞独立生活
B.猴痘病毒属于动物病毒
C.能通过肉眼直接观察
D.结构简单,只由蛋白质组成
B
)A.能离开活细胞独立生活
B.猴痘病毒属于动物病毒
C.能通过肉眼直接观察
D.结构简单,只由蛋白质组成
答案:
B
8. (遵义中考)细菌、真菌、病毒是微生物的主要类群。下列表述正确的是(
A.它们都有细胞核
B.它们都是单细胞生物
C.它们都进行分裂生殖
D.它们一般个体微小、结构简单
D
)A.它们都有细胞核
B.它们都是单细胞生物
C.它们都进行分裂生殖
D.它们一般个体微小、结构简单
答案:
D
9. 某同学发现家里储存的橘子长了青绿色的毛,推测是由青霉生长和繁殖引起的,他对长有青霉的橘子皮进行了观察,并绘制结构图(如图)。下列说法不正确的是(

A.青霉是多细胞真菌
B.①在适宜的环境条件下,能发育成新个体
C.②的细胞内含有叶绿体
D.③能从橘子皮中吸收营养物质
C
)A.青霉是多细胞真菌
B.①在适宜的环境条件下,能发育成新个体
C.②的细胞内含有叶绿体
D.③能从橘子皮中吸收营养物质
答案:
C
10. 下列叙述中,错误的是(
A.蘑菇是多细胞真菌,由菌丝集合而成
B.酵母菌是单细胞真菌,在氧气充足时,能分解葡萄糖产生酒精和二氧化碳
C.细菌是单细胞生物,通过细胞分裂繁殖后代
D.病毒利用寄主细胞内的营养物质,通过复制来繁殖后代
B
)A.蘑菇是多细胞真菌,由菌丝集合而成
B.酵母菌是单细胞真菌,在氧气充足时,能分解葡萄糖产生酒精和二氧化碳
C.细菌是单细胞生物,通过细胞分裂繁殖后代
D.病毒利用寄主细胞内的营养物质,通过复制来繁殖后代
答案:
B
11. 【生命观念】(2024 长沙中考)下图分别为大肠杆菌噬菌体、酵母菌和大肠杆菌的结构示意图,据图回答:

(1) 大肠杆菌噬菌体属于病毒,它没有
(2) 培养酵母菌和大肠杆菌时需向培养液中添加有机物,是因为它们没有
(3) 三种生物形态结构不同,但都有控制发育与遗传的遗传物质,其中酵母菌的遗传物质主要位于
(1) 大肠杆菌噬菌体属于病毒,它没有
细胞结构
,不能独立生活,只能寄生
在大肠杆菌细胞内。(2) 培养酵母菌和大肠杆菌时需向培养液中添加有机物,是因为它们没有
叶绿体
,不能自己制造有机物;控制有机物进入细胞的结构是①
(填序号)。(3) 三种生物形态结构不同,但都有控制发育与遗传的遗传物质,其中酵母菌的遗传物质主要位于
③
(填序号)中。
答案:
(1)细胞结构 寄生
(2)叶绿体 ①
(3)③
(1)细胞结构 寄生
(2)叶绿体 ①
(3)③
查看更多完整答案,请扫码查看